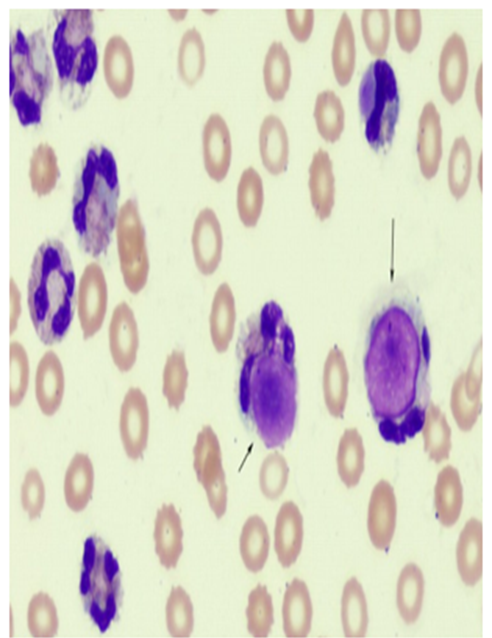

1/28
Looks like no tags are added yet.
Name | Mastery | Learn | Test | Matching | Spaced |
|---|
No study sessions yet.

synovialcytes

A)Ochronotic shards
B)Rice bodies

clot formation in synovial fluid
LE cell

reiter cell

ragocyte

MSU crystals

CPPD crystals

cholestrol crystal

corticosteroid

plasma cells in pleural fluid

abnormal mesothelial cells

normal mesothelial cells

Psammoma body in peritoneal fluid

Macrophages in peritoneal (ascites) fluid

Yeast in peritoneal fluid

Pleural adenocarcinomas

Pleural adenocarcinomas

ovarian carcinoma

lactobacillus

healthy or unhealthy vaginal secretion
healthy

clue cells

clue cells

parabasal body

trichonomads

candidiasis

candidiasis

trichomoniasis

lamellar bodies